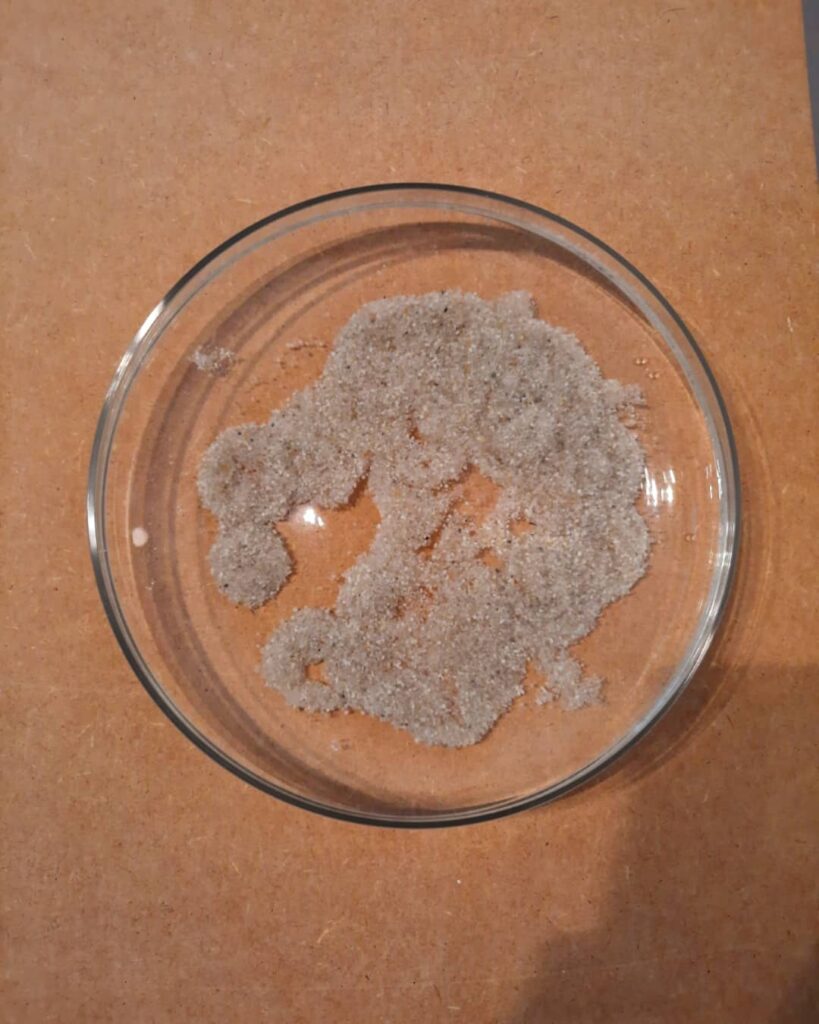
Espaces aléatoires :
à la découverte de nouveaux mondes img 20211110 204333 313

Conception de 21 cartes imaginaires à partir de la fonte de glaçons entrainant la dispersion aléatoire de cristaux de quartz
Novembre 2021
À la frontière entre deux espaces, la cartographie est un outil aux multiples facettes permettant d’osciller entre deux domaines souvent opposés, le réel et l’imaginaire. Une opposition entre deux espaces qui ici disparaît, laissant l’imaginaire se confondre avec le réel.
Inspirées par L’Atlas de Wim Delvoye ainsi que la carte de l’Océan de Lewis Carrol publiée dans La chasse au Snark, ces cartes d’espaces imaginaires trouvent leurs origines dans la répétition d’un protocole précis alliant cristaux de quartz et fonte de glace.
Posés un à un au centre d’un récipient contenant 1 litre d’eau, vingt-et-un glaçons vont dériver et se liquéfier, laissant lentement se disperser les minuscules cristaux de quartz qu’ils renferment. Se dessinant minutes après minutes, des formes s’apparentant à des territoires miniatures apparaissent progressivement au rythme de la disparition des glaçons. Répété vingt-et-une fois, ce protocole permettant la création aléatoire de ces espaces distincts les uns des autres, n’est pourtant que le point de départ de ce travail. Photographiée après la disparition totale des glaçons, chaque forme obtenue est détourée numériquement pour ensuite être cartographiée, faisant alors basculer ces espaces du domaine du réel qui les a vu naître vers un nouveau domaine, celui de l’imaginaire.
Avec une échelle et des légendes indéchiffrables, seul le tracé permet de distinguer des espaces représentés. Des espaces intrigants, sortant du domaine du réel et dont on ne sait ce qu’ils représentent, peut-être de l’eau, des îles, de la roche, ou encore de vastes forêts, rien ne permet avec certitude de déterminer ce qui nous fait face, laissant désormais le spectateur voyager, cartes après cartes, dans les contrées lointaines de l’imaginaire.